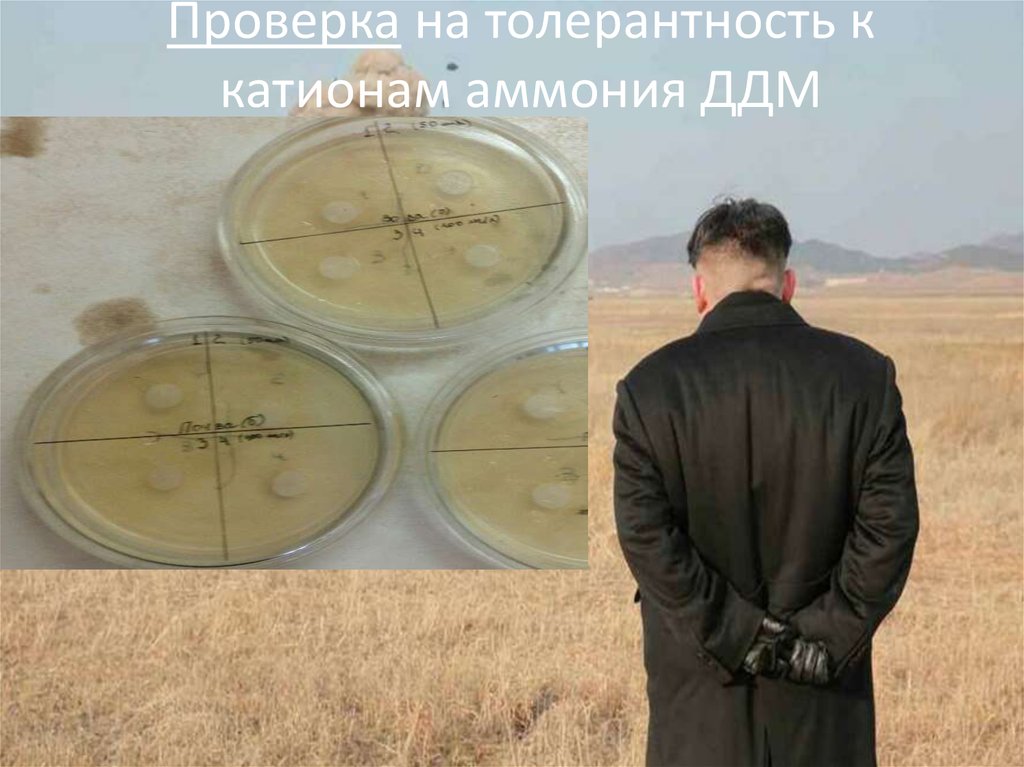
Проверка на толерантность к катионам аммония ДДМ

Similar presentations:
Очистка хозяйственных и сточных вод от азота аммонийного с помощью нитрифицирующих бактерий
1.
Муниципальное бюджетное общеобразовательное учреждение" Лицей №1" г.Пермь
Пермский научно-технический исследовательский политехнический
университет.
Кафедра "Химия и биотехнология".
Направление: химия
"Очистка хозяйственных и сточных вод от азота аммонийного с помощью
нитрифицирующих бактерий"
Работу выполнил
Ученик 202 ß класса
Черемных Павел
Руководитель:
Преподаватель химии и биотехнологии, доцент
Лариса Сергеевна Пан ♥
2. Введение
Россия обладает более 1/5 запаса всей преснойводы. В последние годы отечественные фильтры
не обеспечивают достаточно полной очистки от
азота аммонийного и они достаточно
дорогостоящие.
3. Способы очистки воды от азота аммонийного:
Хлорирование-Образуются хлорамины
-Часть молекулярного хлора остается
Метод отдувки аммиака
-Большой расход электроэнергии
-Сложности эсплуатации в зимнее
врем
-Образование карбоната кальция
на загрузке
Метод обратного осмоса
-Требует тщательной
предварительной очистки
и умягчения воды
Ионный метод
-Много побочных
продуктов
-Используется при конц.
не выше 100 мг/л
Электрохимический метод
-Эффективная очистка только при
добавлении 20% морской воды
4. Цель исследования:
5. Опасности употребления:
Азотааммонийного
• Нарушение функциональности почек, печени,
ЦНС,
• Повышенное артериальное давление
• Изменение pH крови
Нитратов
• Основная опасность нитратов заключается в
том, что в ЖКТ они восстанавливаются до
нитритов, которые в 30 раз более опаснее
нитратов
Нитритов
• Попадая в кровь, нитриты окисляют
гемоглобин крови до метгемоглобина,
который уже не способен переносить
кислород к другим органам
6.
Предельная и действительная концентрация азотав питьевой воде на территории РФ на 06.2012:
ПДК в питьевой воде
Реальный уровень
Нитрит
-анион
(NO2-)
До 1,4 мг/л
До 3,3 мг/л
Нитрат
-анион
(NO3-)
До 44,2 мг/л
До 45 мг/л
Азот
аммон
ийный
(NH4+ )
До 2,6 мг/л
Общий
азот
2 - 8 мг/л
До 7,4 мг/л
До 15 -20 мг/л
7.
Рис.1 М/О, выделенные из почвыРис.2 М/О, выделенные из воды
Не работа, а
РАБОТИЩЕ
(Это не реклама!!!)0)
8. Описание микроорганизмов
Характеристика1 вид
2 вид
Форма колоний
Размер
Оптические
свойства
Цвет
Поверхность
Профиль
Край колоний
Структура колоний
Круглая
Ризоидная
Консистенция
1-2 мм
4 мм
Блестящая
Полупрозрачная
Молочно - белый
Желтый
Гладкая
Гладкая
Выпуклый
Кратерообразный
Гладкий
Волнистый
Однородная
Волокнистая
Маслянистая
Маслянистая
9. Проверка на толерантность к катионам аммония ДДМ
10. Испытание микроорганизмов на NH4+
Время вчасах
С(NH4+)
в мг/л
0
60,1
60,1
С(NO2-)
в мг/л
С(NO3-)
в мг/л
20
24
40
43
39
39,5
37,816
37
36
0,013
0,0125
0,031
0,0304
0,063
0,064
0,090
0,093
3,3
3,3
3,4
3,7
3,8
3,85
3,95
4

chemistry
chemistry








